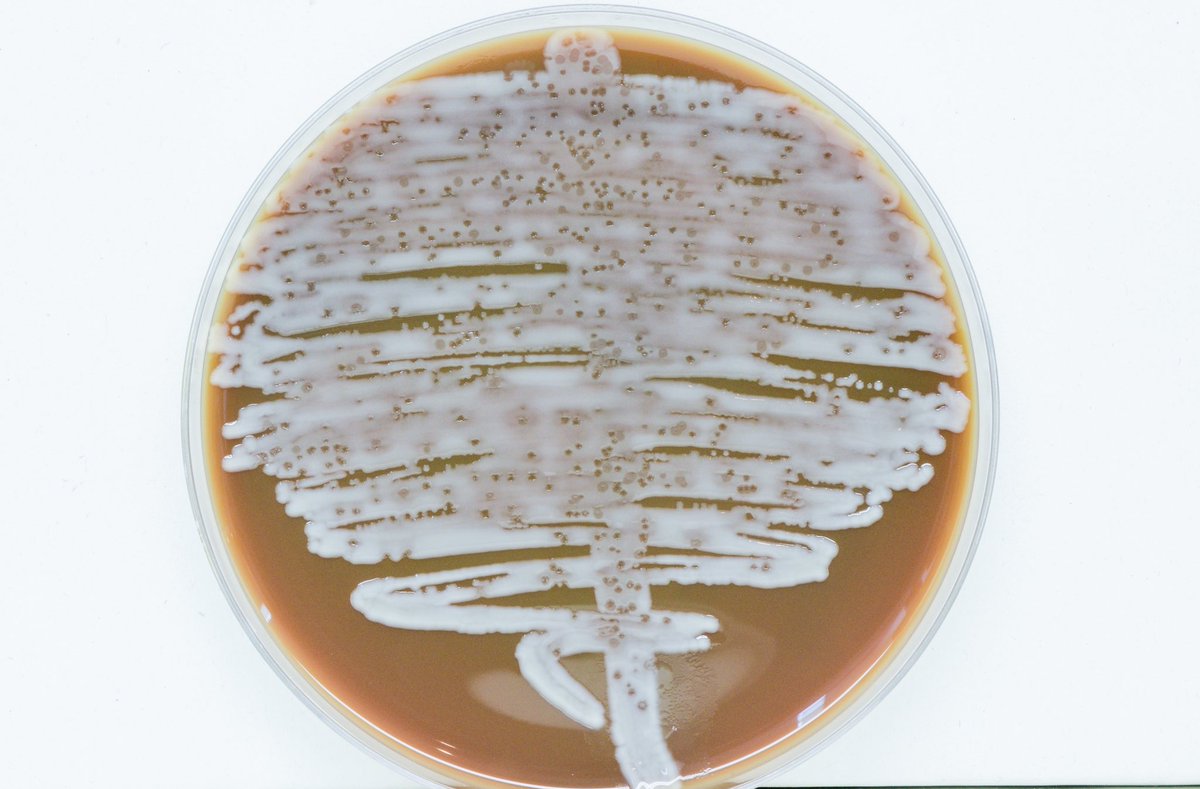
micro_hculb's tweet image. #SaberySembrar
Cultivo de orina en agar chocolate tras 24h de incubación. 
Qué podría explicar este hallazgo?? 🤔

You might like
📹 La participación del equipo inclusivo en el @torneovidaxvida y el trabajo del club, en TVE.
Respeto, compañerismo, integración, esfuerzo y superación son virtudes y valores del deporte. Un ejemplo es el equipo de fútbol inclusivo de la Unión Deportiva Logroñés. @UDLogrones
💪 Así son las sesiones de trabajo, con jugadores del primer equipo (como Daza, Miki o Iñaki) también de 'entrenadores'.
📰 De lectura matinal, el compromiso social del club con su equipo inclusivo: udlogrones.com/25096-2/
👍 Álex Daza, otro jugador del primer equipo que también pone su granito de arena con el inclusivo.

👏 Antes de comenzar el encuentro, Las Gaunas mostró su cariño al equipo inclusivo del club.


🌾 Apoyamos la creación del primer centro tecnológico agroalimentario conjunto de España, con empresas riojanas y navarras. 👉🏼 Fusión del CNTA y FUDin by Ctic Cita. 🗣️ @CapellanGonzalo: “Un sector más competitivo en el Valle del Ebro” 🖇️ Info: actualidad.larioja.org/noticia?n=not-…

Gracias por la visita, @belindaleonf, y por realzar la importancia de impulsar la industria y su competitividad a través de la innovación. @lariojaorg 💪🏻 #FUDinbyCticCita #LaInnovaciónQueConquistaElMercado
Hemos visitado el Centro Tecnológico Empresarial Alimentario (CTIC-CITA) y la semana pasada el Centro Tecnológico del Calzado (CTCR), con sede en Arnedo. Hay un compromiso firme del Ejecutivo regional por reforzar y potenciar estos centros. @lariojaorg




El centro tecnológico @CticCita celebra sus 20 años de éxito en la #TecnologíaAgroalimentaria #FUDin #FoodTech #NuevosAlimentos techpress.es/noticias/ctic-…
Este de @isco_alarcon a Verratti ha sido uno de los caños más sonados del último lustro🔥🔥🔥
#ACOFESAL2022 Nuestro equipo de Calidad y Seguridad Alimentaria está en 📍Madrid en el VI Congreso Internacional de Calidad y Seguridad Alimentaria. 📲 congreso2022.acofesal.org @ACOFESAL1 @AnalizaCalidad #SeguridadAlimentaria ✅

#SaberySembrar Cultivo de orina en agar chocolate tras 24h de incubación. Qué podría explicar este hallazgo?? 🤔
CD Anguiano 🆚 CD Varea 65’ ⏱ | 1-0 | GOOOOOOOLLLLL GOOOOOOOOOOLLLLL GOOOOOOOOOOOOOOOOOOOOOOOOOOOOOOOOOOOOOOOOOOOOOOOOOL DE JOEL!!!!!!
Hoy el inicio del partido ha tenido a unos protagonistas muy especiales: nuestro equipo de fútbol inclusivo, del que tan orgullosos nos sentimos. A causa de la pandemia no han podido participar en torneos, pero son parte de nosotros y contamos con vosotros. ¡Sois enormes! 👏🤍❤️

Es un producto crudo-curado fermentado de origen 100% vegetal que sigue el proceso de elaboración tradicional, conservando el sabor y la apariencia de su homólogo cárnico de origen animal @CticCita rioja2.com/n-162149-2-el-…
Hoy #DíaInternacionalDeLaMujer celebramos el #TalentoFemenino que hay en nuestra organización, porque #CticCita gracias a su política de #igualdad, promoción de la carrera profesional y conciliación familiar, cuenta con una plantilla integrada en un 60% por mujeres. #8Marzo2022

Todavía no nos lo podemos creer! 👏👏😊 Nuestro Oveja Curado medalla de oro🥇 con 99,72 puntos sobre 100 y un excelente puesto Top 20 entre las casi tres mil referencias presentadas al World Championship Cheese Contest, siendo el único queso español! 🥰 europapress.es/la-rioja/notic…
europapress.es
El queso de oveja curado Los Cameros, ganador en su categoría del...
Medalla de oro, y con un excelente puesto Top 20 entre las 2.919 referencias presentadas a concurso (el...
Universidad de Salamanca. Facultad de biología. Dejaron 2 cristales mal sellados y entró agua. Han pasado cosas. Son biólogos y se nota. Leed el cartel.

La terapia de #fagos es una realidad en la lucha contra bacterias multirresistentes, especialmente #Klebsiella, y desde el #EnBiVirLab avanzamos en esta dirección @i2sysbio @UV_EG @CSIC
🔴 ÚLTIMA HORA | Una mujer supera una de las peores infecciones conocidas gracias a un tratamiento con virus bit.ly/3rpUV6Z
👤🗓️ Hoy ha tenido lugar la jornada FUDin Tech Summit 2021 organizada por @CticCita, en la que ha participado el Secretario Técnico de la PT @Food4LifeSPAIN Juan Martínez Gironella hablando sobre actividades y oportunidades de la Plataforma. ▶️ foodforlife-spain.es



Hemos participado en un encuentro muy especial para @PLENALARIOJA Hemos estado en @ziniobodegas con nuestros cómplices @CticCita que han presentado el proyecto: 'Somos empresa Cómplice. Desarrollo de nuevos productos adaptados a personas con discapacidad intelectual'. Gracias




United States Trends
- 1. The VIRTUALS PROTOCOL N/A
- 2. FINALLY DID IT N/A
- 3. Ryan Wedding N/A
- 4. The SPX6900 N/A
- 5. #FanCashDropPromotion N/A
- 6. AMERICAN GIRLS N/A
- 7. The Paxos Global N/A
- 8. #FridayVibes N/A
- 9. Good Friday N/A
- 10. #FursuitFriday N/A
- 11. JS AVOCEAN FAM SIGN N/A
- 12. #สนามอ่านเล่น2026xJimmySea N/A
- 13. 1.3 SOL N/A
- 14. Pettine N/A
- 15. The ONDO N/A
- 16. Autopilot N/A
- 17. The REKT N/A
- 18. Ari Lennox N/A
- 19. #23Ene N/A
- 20. Happy Friyay N/A
You might like
-
 C.D. Anguiano
C.D. Anguiano
@CDAnguiano_ -
 Ricardo Pascual
Ricardo Pascual
@Richipascua -
 Javi Adán🍇
Javi Adán🍇
@JaviAdan81 -
 antonio corral
antonio corral
@antoniocorral47 -
 Vicente Elias Ruiz
Vicente Elias Ruiz
@vicenteeliasrui -
 UD Logroñés Cantera
UD Logroñés Cantera
@CanteraUDLog -
 Neila
Neila
@neila87 -
 dani delgado
dani delgado
@danidel85 -
 Pablo Sabando
Pablo Sabando
@pablosabando -
 Ricardo Pison
Ricardo Pison
@richipison -
 david perez perez
david perez perez
@PerezEntredavid -
 Herminio Rueda
Herminio Rueda
@valdevenados -
 Adrián Gallego
Adrián Gallego
@adrianghervias -
 Victor Lopez Cid
Victor Lopez Cid
@viticidlopez
Something went wrong.
Something went wrong.

































































































































